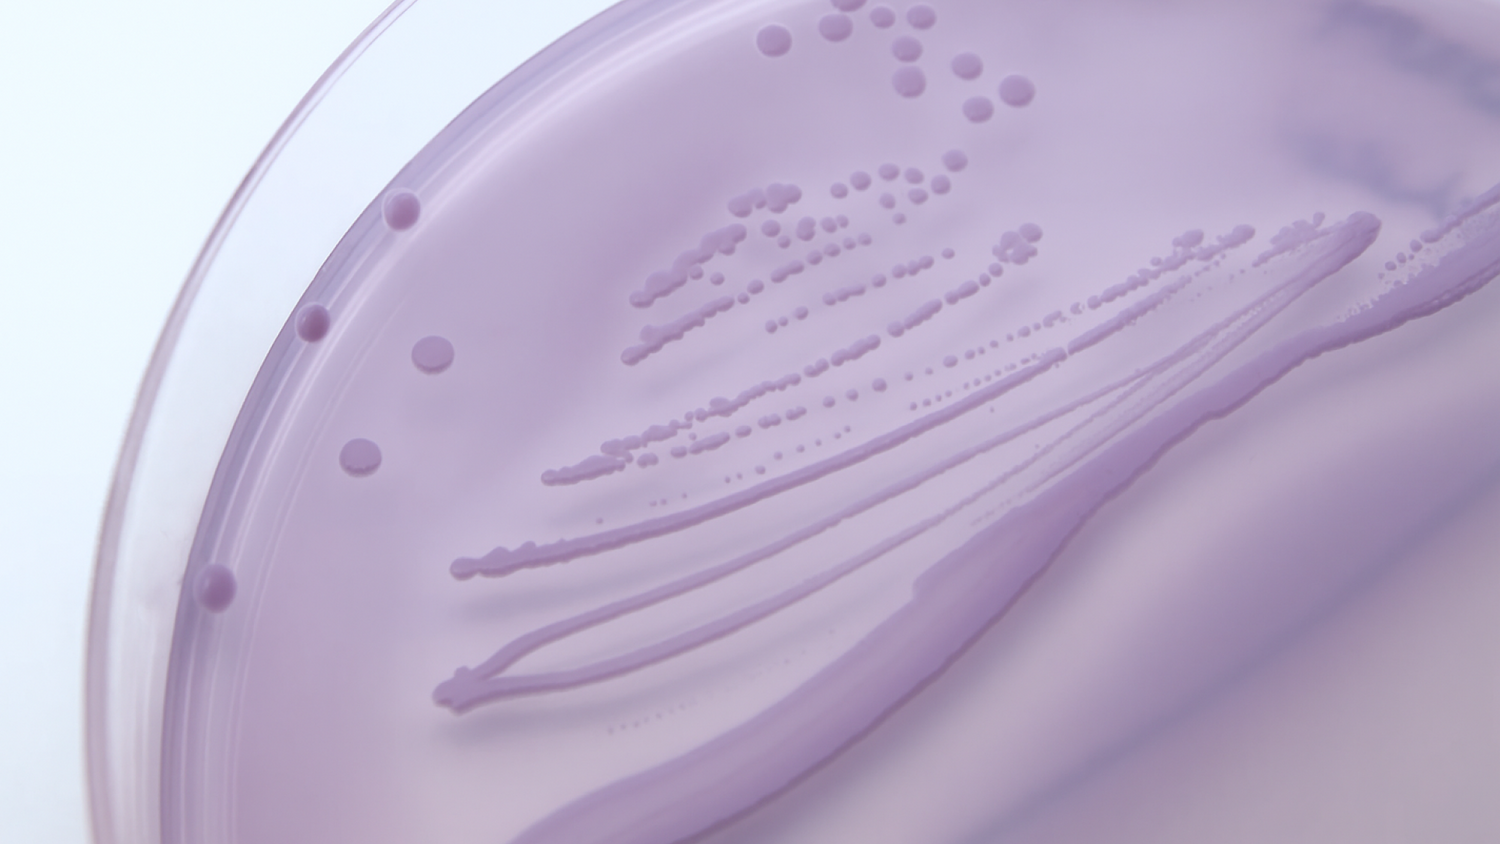

Are at-home UTI tests accurate? Here’s what you need to know
Like any at-home illness or infection test kit, there are myths surrounding the accuracy of urinary tract infection (UTI) screening tests that you administer yourself – namely, that they don’t...